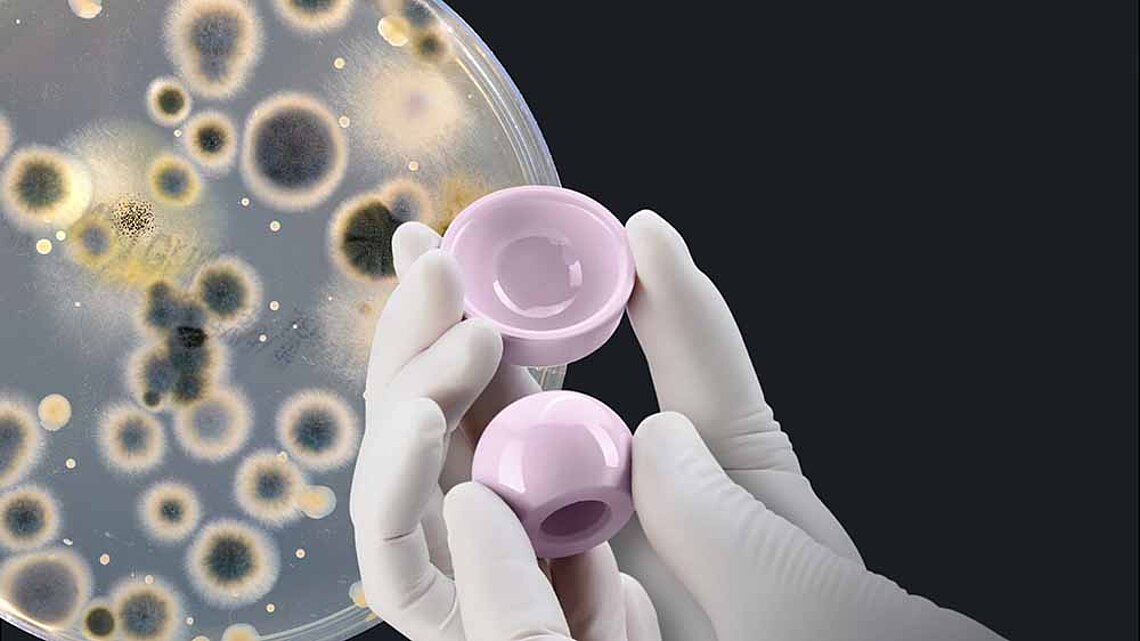

Deutlich weniger Revisionen in der HTEP mit Keramik
Die Verwendung von Keramikgleitpaarungen geht mit einer signifikanten Reduzierung von Hüftrevisionen im Vergleich zu Metall-Polyethylen-Gleitpaarungen (MoP) einher. Dies ist das Ergebnis einer aktuellen Beobachtungsstudie (2021), die im Journal of Arthroplasty veröffentlicht wurde. Holleyman et al. (Newcastle, UK) haben Daten aus dem National Joint Registry der UK (NJR) (Zeitraum: 2002 - 2016) von mehr als 456.000 erwachsenen Patienten ausgewertet, die sich einer HTEP unterzogen haben. Die Patienten wurden entweder mit einer Keramik/Keramik-Gleitpaarung (CoC) (128.403 Patienten), einer Keramik/Polyethylen-Gleitpaarung (CoP) (99.268 Patienten) oder einer Metall/Polyethylen-Gleitpaarung (MoP) (228.786 Patienten) behandelt. Die Autoren untersuchten die Revisionsraten für drei Kategorien von Revisionen - Revisionen aller Ursachen, Infektionen und aseptische Lockerungen - unter Berücksichtigung der verschiedenen Gleitpaarungen, des Alters, des Geschlechts, des ASA-Grades (American Society of Anaesthesiologists), des Body-Mass-Index (BMI), chirurgische Indikation, intraoperative Komplikationen und Implantatdaten.
Ihre wichtigsten Ergebnisse waren: "Die Verwendung einer keramischen Gleitpaarung hat einen signifikanten Schutzeffekt in Bezug auf Revisionen nach primärer HTEP im Vergleich zu MoP, vor allem nach 2 Jahren nach der Implantation". Dieser Effekt ist nachweislich am stärksten bei Revisionen aufgrund von Infektionen. Keramikgleitpaarungen wurden mit einer signifikanten Reduktion der Revisionen aufgrund von Infektionen im Vergleich zu MoP-Gleitpaarungen in Verbindung gebracht: -25,2 % mit CoC und -22,5 % mit CoP. Bei Revisionen aller Ursachen betrug der Rückgang 8,2 % bei CoC und 19,4 % bei CoP im Vergleich zu Metallgleitlagern, und die aseptische Lockerung wurde um 18,1 % bei CoC und 24,8 % bei CoP reduziert.
Nach Ansicht der Autoren werden diese Daten den Chirurgen bei der Auswahl einer geeigneten Gleitpaarung helfen und somit möglicherweise erhebliche Kosteneinsparungen für das Gesundheitssystem ermöglichen.
Referenz: R. Holleyman et al., The Journal of Arthroplasty, June 2021, DOI:https://doi.org/10.1016/j.arth.2021.05.027